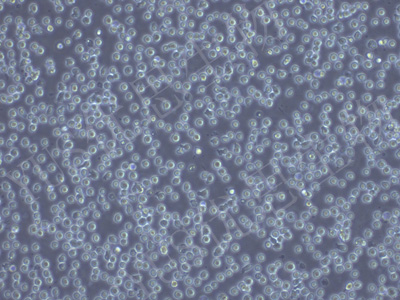
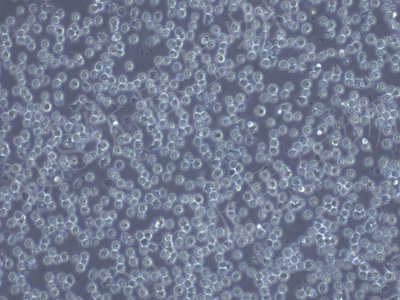

产品中心
产品中心
-

LC-2/ad 人肺腺癌细胞(STR鉴定)
货号:YLH604规格: 1*10^6 -

CCF-STTG1 人脑星形胶质细胞瘤细胞(STR鉴定)
货号:YLH605规格: 1*10^6 -

Granta-519 人类B细胞淋巴癌(STR鉴定)
货号:YLH606规格: 1*10^6 -
CA46 人Burkitt's淋巴瘤细胞(STR鉴定)
货号:YLH607规格: 1*10^6 -
CoC1-DDP 人卵巢癌细胞CoC1顺铂耐药株(STR鉴定)
货号:YLH608规格: 1*10^6 -

NAMALWA 人Burkitt's淋巴瘤细胞(STR鉴定)
货号:YLH609规格: 1*10^6 -

NCI-H2087 人非小细胞肺腺癌细胞(STR鉴定)
货号:YLH610规格: 1*10^6 -

SF763 人脑瘤细胞(STR鉴定)
货号:YLH611规格: 1*10^6 -

HT-3 人子宫颈癌细胞(STR鉴定)
货号:YLH612规格: 1*10^6 -

NCI-H1563 人非小细胞肺癌细胞(STR鉴定)
货号:YLH613规格: 1*10^6 -

HARA-B 人肺鳞状细胞癌细胞(STR鉴定)
货号:YLH614规格: 1*10^6 -

TK6 人成淋巴细胞(STR鉴定)
货号:YLH615规格: 1*10^6
在线咨询
Online consultation

关注微信公众号


